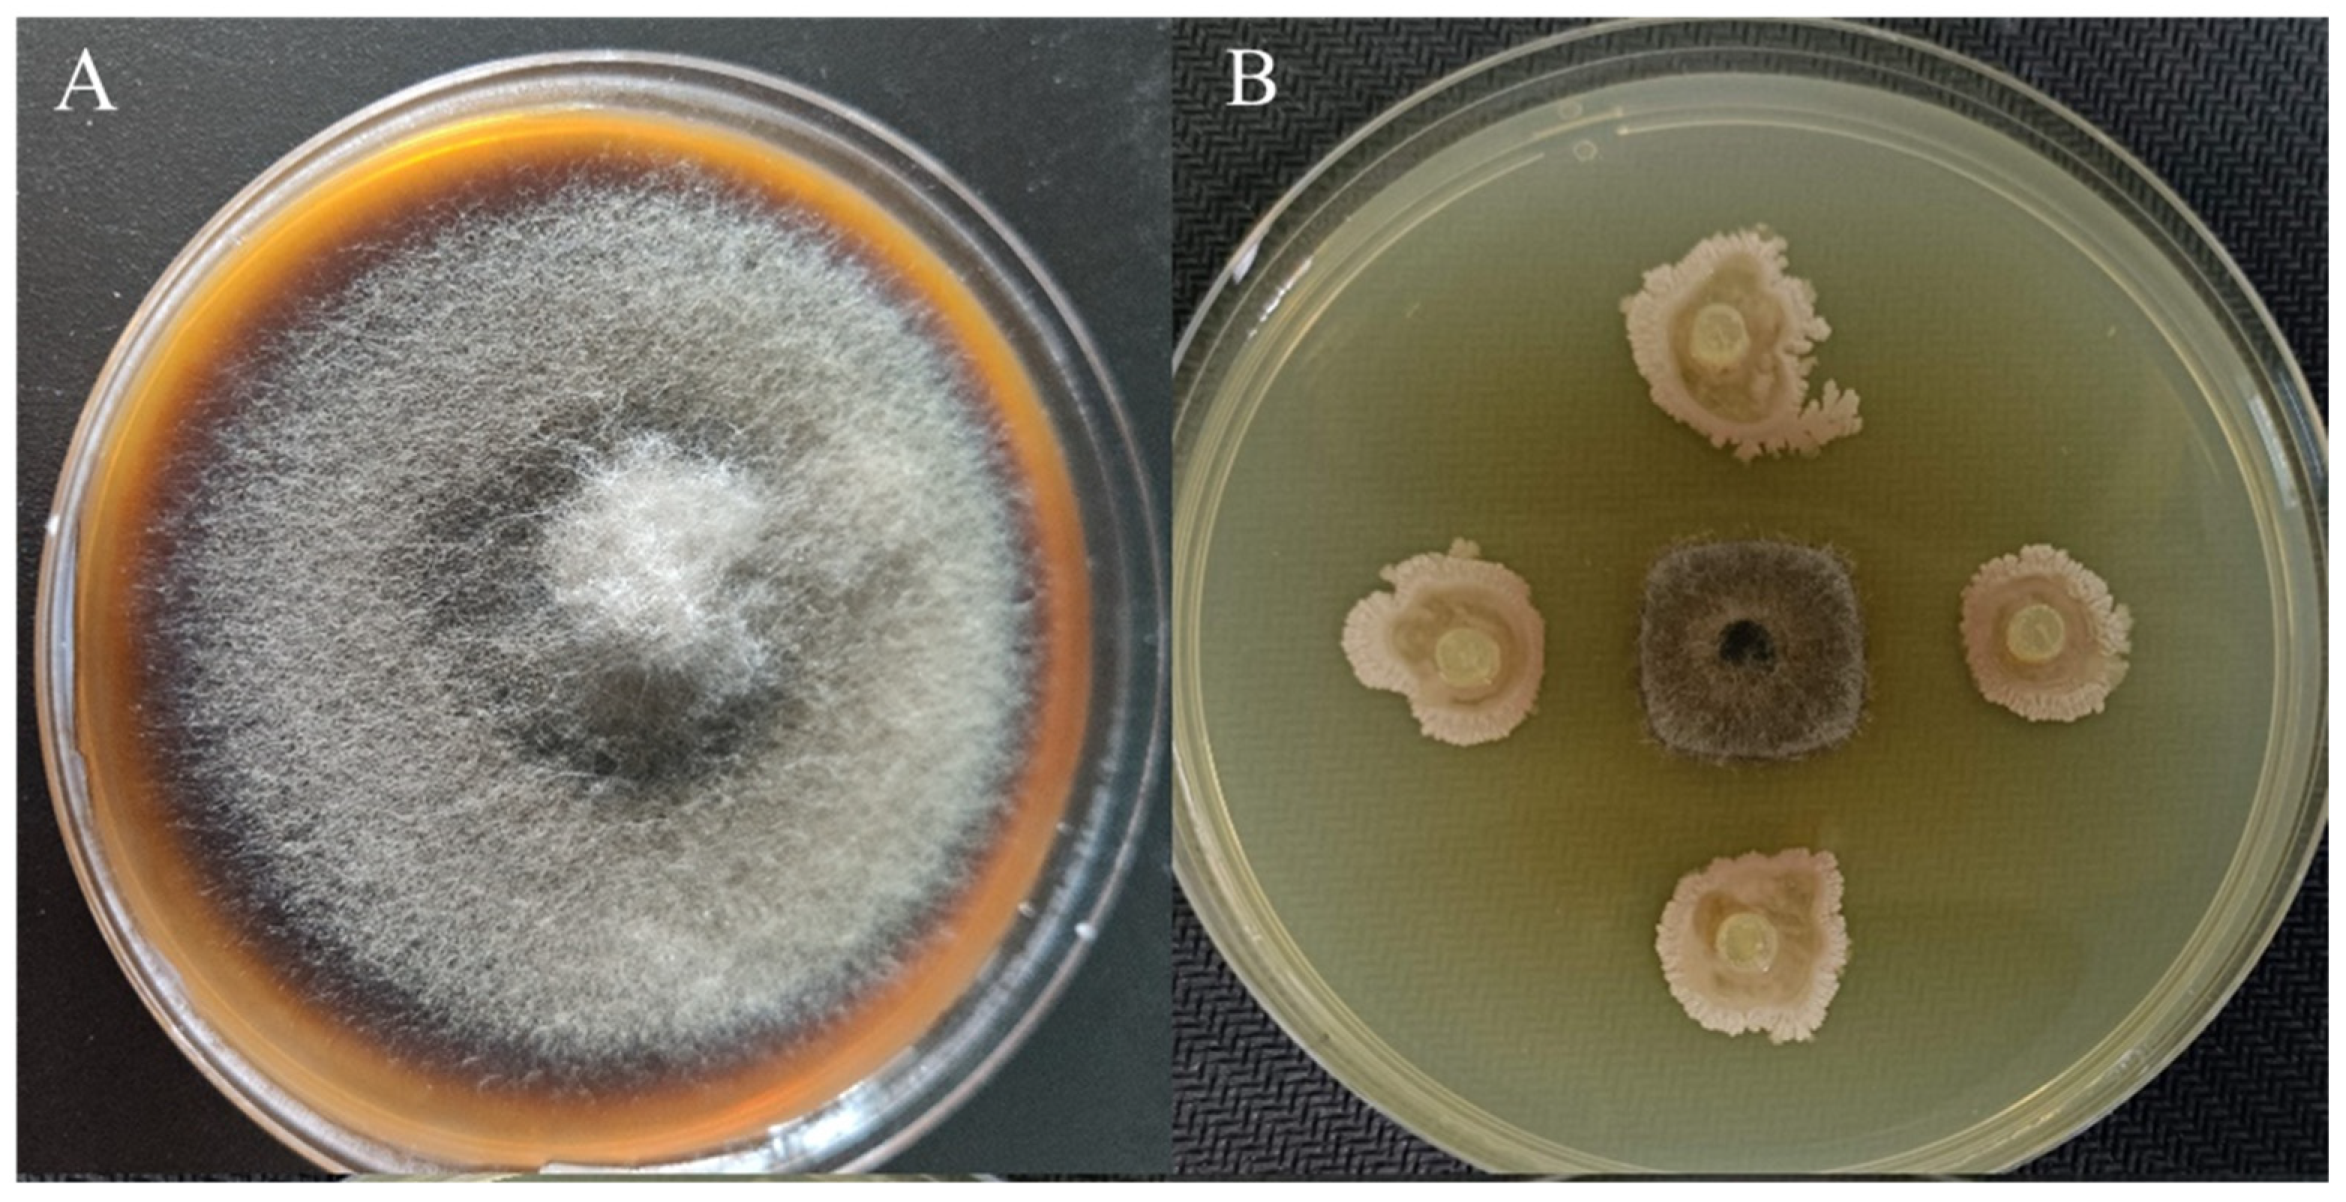
Microorganisms 12 00921 g001

Bacillus velezensis YXDHD1-7 Prevents Early Blight Disease by Promoting Growth and Enhancing Defense Enzyme Activities in Tomato Plants
Abstract
1. Introduction
2. Materials and Methods
2.1. Strain Isolation
2.2. Screening and Identification of Antagonistic Strains
2.3. Indole Acetic Acid (IAA) Assay
2.4. Tomato Seed Germination Experiments
2.5. Antagonistic Effects on Tomato Leaves In Vitro
2.6. Greenhouse Bioassay
2.6.1. Greenhouse Bioassay to Test Growth-Promoting Effects
2.6.2. Greenhouse Bioassay for Biocontrol
2.7. Enzymatic Activity
2.8. Genome Sequencing and Analysis
3. Results
3.1. Screening of the Antagonistic Activity of Strains and Determination of IAA Content
3.2. Effects of YXDHD1-7 on Tomato Seed Germination
3.3. Effects of the In Vitro YXDHD1-7 Treatment on Detached Infected Tomato Leaves
3.4. Greenhouse Bioassay for Growth Promotion and the Ability of YXDHD1-7 to Prevent Disease
3.4.1. Effect of Strain YXDHD1-7 on Tomato Seedling Growth
3.4.2. Effects of Strain YXDHD1-7 on Tomato Early Blight
3.4.3. Effects of Strain YXDHD1-7 on the Activity of Defense Enzymes in Tomato Leaves
3.5. Genome Sequencing of Strain YXDHD1-7
3.5.1. Genomic Features
3.5.2. Genetic Basis for the Plant Growth-Promoting and Anti-Pathogen Effects of YXDHD1-7
4. Discussion
5. Conclusions
Supplementary Materials
Author Contributions
Funding
Data Availability Statement
Conflicts of Interest
References
- Pandey, K.; Pandey, P. Survey and surveillance of vegetable growing areas for prevalence of major diseases. Veg. Sci. 2003, 30, 128–134. [Google Scholar]
- Tan, H.; Zhou, S.; Deng, Z.; He, M.; Cao, L. Ribosomal-sequence-directed selection for endophytic streptomycete strains antagonistic to Ralstonia solanacearum to control tomato bacterial wilt. Biol. Control 2011, 59, 245–254. [Google Scholar] [CrossRef]
- Nayyar, B.G.; Akhund, S.; Akram, A. A review: Management of Alternaria and its mycotoxins in crops. Int. J. Adv. Appl. Sci. 2014, 3, 432–437. [Google Scholar] [CrossRef]
- Martinko, K.; Ivanković, S.; Lazarević, B.; Đermić, E.; Đermić, D. Control of early blight fungus (Alternaria alternata) in tomato by boric and phenylboronic acid. Antibiotics 2022, 11, 320. [Google Scholar] [CrossRef] [PubMed]
- Chaerani, R.; Voorrips, R.E. Tomato early blight (Alternaria solani): The pathogen, genetics, and breeding for resistance. J. Gen. Plant Pathol. 2006, 72, 335–347. [Google Scholar] [CrossRef]
- Paramanandham, P.; Rajkumari, J.; Pattnaik, S.; Busi, S. Biocontrol potential against Fusarium oxysporum f. sp. lycopersici and Alternaria solani and tomato plant growth due to plant growth–promoting rhizobacteria. Int. J. Veg. Sci. 2017, 23, 294–303. [Google Scholar] [CrossRef]
- Prashar, P.; Kapoor, N.; Sachdeva, S. Biocontrol of plant pathogens using plant growth promoting bacteria. Sustain. Agric. Rev. 2013, 12, 319–360. [Google Scholar]
- Islam, S.; Akanda, A.M.; Prova, A.; Islam, M.T.; Hossain, M.M. Isolation and identification of plant growth promoting rhizobacteria from cucumber rhizosphere and their effect on plant growth promotion and disease suppression. Front. Microbiol. 2016, 6, 165532. [Google Scholar] [CrossRef]
- Boyno, G.; Demir, S.; Danesh, Y.R. Effects of some biological agents on the growth and biochemical parameters of tomato plants infected with Alternaria solani (Ellis & Martin) Sorauer. Eur. J. Plant Pathol. 2022, 162, 19–29. [Google Scholar]
- Maurya, S.; Regar, R.; Kumar, S.; Dubey, S. Management tactics for early blight of tomato caused by Alternaria solani: A review. J. Plant Biol. Crop Res. 2022, 5, 1062. [Google Scholar]
- Kumar, A.; Rana, T.; Goutam, E.; Prakash, S.; Koshariya, A.K. Evidences of induced resistance in tomato against Alternaria solani: An investigation. Trends Hortic. 2023, 6, 2677. [Google Scholar] [CrossRef]
- Raupach, G.S.; Kloepper, J.W. Mixtures of plant growth-promoting rhizobacteria enhance biological control of multiple cucumber pathogens. Phytopathology 1998, 88, 1158–1164. [Google Scholar] [CrossRef] [PubMed]
- Chen, Q.; Wang, H. Biocontrol activity and action mechanism of Bacillus velezensis strain SDTB038 against Fusarium crown and root rot of tomato. Front. Microbiol. 2022, 13, 994716. [Google Scholar] [CrossRef] [PubMed]
- Mu, F.; Chen, X.; Fu, Z.; Wang, X.; Guo, J.; Zhao, X.; Zhang, B. Genome and transcriptome analysis to elucidate the biocontrol mechanism of Bacillus amyloliquefaciens XJ5 against Alternaria solani. Microorganisms 2023, 11, 2055. [Google Scholar] [CrossRef] [PubMed]
- Li, S.; Xiao, Q.; Yang, H.; Huang, J.; Li, Y. Characterization of a new Bacillus velezensis as a powerful biocontrol agent against tomato gray mold. Pestic. Biochem. Physiol. 2022, 187, 105199. [Google Scholar] [CrossRef] [PubMed]
- Zaid, D.S.; Cai, S.; Hu, C.; Li, Z.; Li, Y. Comparative genome analysis reveals phylogenetic identity of Bacillus velezensis HNA3 and genomic insights into its plant growth promotion and biocontrol effects. Microbiol. Spectr. 2022, 10, e02169-21. [Google Scholar] [CrossRef] [PubMed]
- Wen, T.; Ding, Z.; Thomashow, L.S.; Hale, L.; Yang, S.; Xie, P.; Liu, X.; Wang, H.; Shen, Q.; Yuan, J. Deciphering the mechanism of fungal pathogen-induced disease-suppressive soil. New Phytol. 2023, 238, 2634–2650. [Google Scholar] [CrossRef] [PubMed]
- Xu, J.; Zheng, Y.; Peng, D.; Shao, Y.; Li, R.; Li, W. Bacillus siamensis N-1 improves fruit quality and disease resistance by regulating ROS homeostasis and defense enzyme activities in pitaya. Sci. Hortic. 2024, 329, 112975. [Google Scholar] [CrossRef]
- Fincheira, P.; Venthur, H.; Mutis, A.; Parada, M.; Quiroz, A. Growth promotion of Lactuca sativa in response to volatile organic compounds emitted from diverse bacterial species. Microbiol. Res. 2016, 193, 39–47. [Google Scholar] [CrossRef]
- Peng, G.; Zhao, X.; Li, Y.; Wang, R.; Huang, Y.; Qi, G. Engineering Bacillus velezensis with high production of acetoin primes strong induced systemic resistance in Arabidopsis thaliana. Microbiol. Res. 2019, 227, 126297. [Google Scholar] [CrossRef]
- Zhang, X.; Zheng, X.; Han, Y.; Yang, R.; Wang, Q.; Gong, D.; Li, Y.; Prusky, D.; Bi, Y. UV-C irradiation maintains cell membrane integrity at wounds of potato tubers during healing by regulating ROS homeostasis and increasing antioxidant activity. Postharvest Biol. Technol. 2023, 199, 112308. [Google Scholar] [CrossRef]
- Shi, Z.; Wang, F.; Lu, Y.; Deng, J. Combination of chitosan and salicylic acid to control postharvest green mold caused by Penicillium digitatum in grapefruit fruit. Sci. Hortic. 2018, 233, 54–60. [Google Scholar] [CrossRef]
- Kim, D.S.; Hwang, B.K. An important role of the pepper phenylalanine ammonia-lyase gene (PAL1) in salicylic acid-dependent signalling of the defence response to microbial pathogens. J. Exp. Bot. 2014, 65, 2295–2306. [Google Scholar] [CrossRef] [PubMed]
- Kim, S.W.; Jung, J.H.; Lamsal, K.; Kim, Y.S.; Min, J.S.; Lee, Y.S. Antifungal effects of silver nanoparticles (AgNPs) against various plant pathogenic fungi. Mycobiology 2012, 40, 53–58. [Google Scholar] [CrossRef]
- Hugh, R.; Leifson, E. The taxonomic significance of fermentative versus oxidative metabolism of carbohydrates by various gram negative bacteria. J. Bacteriol. 1953, 66, 24–26. [Google Scholar] [CrossRef] [PubMed]
- Ehmann, A. The Van Urk-Salkowski reagent—A sensitive and specific chromogenic reagent for silica gel thin-layer chromatographic detection and identification of indole derivatives. J. Chromatogr. A 1977, 132, 267–276. [Google Scholar] [CrossRef]
- Vloutoglou, I.; Kalogerakis, S. Effects of inoculum concentration, wetness duration and plant age on development of early blight (Alternaria solani) and on shedding of leaves in tomato plants. Plant Pathol. 2000, 49, 339–345. [Google Scholar] [CrossRef]
- Roberts, D.; Denny, T.; Schell, M. Cloning of the egl gene of Pseudomonas solanacearum and analysis of its role in phytopathogenicity. J. Bacteriol. 1988, 170, 1445–1451. [Google Scholar] [CrossRef] [PubMed]
- Meitei, K.M.; Bora, G.; Borah, P. Screening of tomato genotypes for resistance to early blight (Alternaria Solani). ARS 2012, 19, 7064. [Google Scholar]
- Guo, Y.; Zhou, J.; Zhang, J.; Zhang, S. Chitosan combined with sodium silicate treatment induces resistance against rot caused by Alternaria alternata in postharvest jujube fruit. J. Phytopathol. 2019, 167, 451–460. [Google Scholar] [CrossRef]
- Gao, S.; Ouyang, C.; Wang, S.; Xu, Y.; Tang, L.; Chen, F. Effects of salt stress on growth, antioxidant enzyme and phenylalanine ammonia-lyase activities in Jatropha curcas L. seedlings. Plant Soil Environ. 2008, 54, 374–381. [Google Scholar] [CrossRef]
- Muñoz-Villagrán, C.; Grossolli-Gálvez, J.; Acevedo-Arbunic, J.; Valenzuela, X.; Ferrer, A.; Díez, B.; Levicán, G. Characterization and genomic analysis of two novel psychrotolerant Acidithiobacillus ferrooxidans strains from polar and subpolar environments. Front. Microbiol. 2022, 13, 960324. [Google Scholar] [CrossRef]
- Mende, D.R.; Sunagawa, S.; Zeller, G.; Bork, P. Accurate and universal delineation of prokaryotic species. Nat. Methods 2013, 10, 881–884. [Google Scholar] [CrossRef] [PubMed]
- Wang, D.; Poinsot, V.; Li, W.; Lu, Y.; Liu, C.; Li, Y.; Xie, K.; Sun, L.; Shi, C.; Peng, H. Genomic insights and functional analysis reveal plant growth promotion traits of Paenibacillus mucilaginosus G78. Genes 2023, 14, 392. [Google Scholar] [CrossRef] [PubMed]
- Lee, B.; Farag, M.A.; Park, H.B.; Kloepper, J.W.; Lee, S.H.; Ryu, C.-M. Induced resistance by a long-chain bacterial volatile: Elicitation of plant systemic defense by a C13 volatile produced by Paenibacillus polymyxa. PLoS ONE 2012, 7, e48744. [Google Scholar] [CrossRef] [PubMed]
- Gopalakrishnan, S.; Sathya, A.; Vijayabharathi, R.; Varshney, R.K.; Gowda, C.L.; Krishnamurthy, L. Plant growth promoting rhizobia: Challenges and opportunities. 3 Biotech 2015, 5, 355–377. [Google Scholar] [CrossRef] [PubMed]
- Hu, L.; Xiang, L.; Li, S.; Zou, Z.; Hu, X.H. Beneficial role of spermidine in chlorophyll metabolism and D1 protein content in tomato seedlings under salinity–alkalinity stress. Physiol. Plant. 2016, 156, 468–477. [Google Scholar] [CrossRef] [PubMed]
- Awadalla, O.A. Induction of systemic acquired resistance in tomato plants against early blight disease. Egypt. J. Exp. Biol. (Bot.) 2008, 4, 53–59. [Google Scholar]
- Fan, B.; Wang, C.; Song, X.; Ding, X.; Wu, L.; Wu, H.; Gao, X.; Borriss, R. Bacillus velezensis FZB42 in 2018: The gram-positive model strain for plant growth promotion and biocontrol. Front. Microbiol. 2018, 9, 408393. [Google Scholar] [CrossRef]
- Myo, E.M.; Liu, B.; Ma, J.; Shi, L.; Jiang, M.; Zhang, K.; Ge, B. Evaluation of Bacillus velezensis NKG-2 for bio-control activities against fungal diseases and potential plant growth promotion. Biol. Control 2019, 134, 23–31. [Google Scholar] [CrossRef]
- Rabbee, M.F.; Hwang, B.-S.; Baek, K.-H. Bacillus velezensis: A beneficial biocontrol agent or facultative phytopathogen for sustainable agriculture. Agronomy 2023, 13, 840. [Google Scholar] [CrossRef]
- Gao, Z.; Zhang, B.; Liu, H.; Han, J.; Zhang, Y. Identification of endophytic Bacillus velezensis ZSY-1 strain and antifungal activity of its volatile compounds against Alternaria solani and Botrytis cinerea. Biol. Control 2017, 105, 27–39. [Google Scholar] [CrossRef]
- Ren, L.; Zhou, J.; Yin, H.; Qin, N.; Yao, F.; Ma, D.; Zhao, X. Antifungal activity and control efficiency of endophytic Bacillus velezensis ZJ1 strain and its volatile compounds against Alternaria solani and Botrytis cinerea. J. Plant Pathol. 2022, 104, 575–589. [Google Scholar] [CrossRef]
- Zhang, D.; Yu, S.; Zhao, D.; Zhang, J.; Pan, Y.; Yang, Y.; Yang, Z.; Zhu, J.; Zhao, Y.; Li, R. Inhibitory effects of non-volatiles lipopeptides and volatiles ketones metabolites secreted by Bacillus velezensis C16 against Alternaria solani. Biol. Control 2021, 152, 104421. [Google Scholar] [CrossRef]
- Chen, L.; Shi, H.; Heng, J.; Wang, D.; Bian, K. Antimicrobial, plant growth-promoting and genomic properties of the peanut endophyte Bacillus velezensis LDO2. Microbiol. Res. 2019, 218, 41–48. [Google Scholar] [CrossRef] [PubMed]
- Bai, X.; Li, Q.; Zhang, D.; Zhao, Y.; Zhao, D.; Pan, Y.; Wang, J.; Yang, Z.; Zhu, J. Bacillus velezensis strain HN-Q-8 induced resistance to Alternaria solani and stimulated growth of potato plant. Biology 2023, 12, 856. [Google Scholar] [CrossRef]
- Zhang, X.; Kong, W.; Wu, X.; Ye, J. Bacillus velezensis JK-XZ8 prevents and controls crown gall disease on Prunus subhirtella by colonizing and inducing resistance. J. For. Res. 2022, 33, 1019–1031. [Google Scholar] [CrossRef]
- Pal, G.; Saxena, S.; Kumar, K.; Verma, A.; Kumar, D.; Shukla, P.; Pandey, A.; Verma, S.K. Seed endophytic bacterium Bacillus velezensis and its lipopeptides acts as elicitors of defense responses against Fusarium verticillioides in maize seedlings. Plant Soil 2023, 492, 109–124. [Google Scholar] [CrossRef]
- Yan, Y.; Xu, W.; Hu, Y.; Tian, R.; Wang, Z. Bacillus velezensis YYC promotes tomato growth and induces resistance against bacterial wilt. Biol. Control 2022, 172, 104977. [Google Scholar] [CrossRef]
- Ryu, C.-M.; Farag, M.A.; Hu, C.-H.; Reddy, M.S.; Wei, H.-X.; Paré, P.W.; Kloepper, J.W. Bacterial volatiles promote growth in Arabidopsis. Proc. Natl. Acad. Sci. USA 2003, 100, 4927–4932. [Google Scholar] [CrossRef]
- Ryu, C.-M.; Farag, M.A.; Hu, C.-H.; Reddy, M.S.; Kloepper, J.W.; Paré, P.W. Bacterial volatiles induce systemic resistance in Arabidopsis. Plant Physiol. 2004, 134, 1017–1026. [Google Scholar] [CrossRef] [PubMed]
- Rudrappa, T.; Biedrzycki, M.L.; Kunjeti, S.G.; Donofrio, N.M.; Czymmek, K.J.; Paul, W.P.; Bais, H.P. The rhizobacterial elicitor acetoin induces systemic resistance in Arabidopsis thaliana. Commun. Integr. Biol. 2010, 3, 130–138. [Google Scholar] [CrossRef] [PubMed]
- Renna, M.C.; Najimudin, N.; Winik, L.; Zahler, S. Regulation of the Bacillus subtilis alsS, alsD, and alsR genes involved in post-exponential-phase production of acetoin. J. Bacteriol. 1993, 175, 3863–3875. [Google Scholar] [CrossRef] [PubMed]
- Chung, J.-h.; Song, G.C.; Ryu, C.-M. Sweet scents from good bacteria: Case studies on bacterial volatile compounds for plant growth and immunity. Plant Mol. Biol. 2016, 90, 677–687. [Google Scholar] [CrossRef]
- Meng, Q.; Jiang, H.; Hao, J.J. Effects of Bacillus velezensis strain BAC03 in promoting plant growth. Biol. Control 2016, 98, 18–26. [Google Scholar] [CrossRef]

| IAA (mg/L) | A. asolani | F. oxysporum f. sp. momordicae | F. oxysporum f. sp. cubense | R. solanacearum (Tomato) | R. solanacearum (Pepper) |
|---|---|---|---|---|---|
| 25.51 ± 1.55 | Inhibition rate (%) | Inhibition zone (mm) | |||
| 80.08 ± 0.15 | 52.01 ± 1.08 | 54.27 ± 2.27 | 19.34 ± 0.13 | 14.20 ± 1.29 | |
| Treatments | Bud Length (mm) | Root Length (mm) | Germination Rate (%) |
|---|---|---|---|
| CK | 9.39 ± 2.29 b | 18.90 ± 6.98 c | 93.33 ± 5.77 a |
| 106 | 15.30 ± 4.12 a | 40.22 ± 10.03 a | 96.67 ± 5.77 a |
| 107 | 9.62 ± 3.79 b | 25.72 ± 9.56 b | 90.00 ± 0.01 a |
| Treatment | Infection Rate (%) | Percent Disease Index (PDI) (%) | Relative Control Rate (%) |
|---|---|---|---|
| AS | 100.00 ± 0 | 99.67 ± 0.47 | - |
| AS + BV-106 | 72.50 ± 2.5 | 18.42 ± 0.31 | 81.39 ± 0.14 |
| AS + BV-107 | 100.00 ± 0 | 42.25 ± 1.62 | 56.93 ± 0.63 |
| AS + BV-108 | 100.00± 0 | 86.50 ± 1.08 | 12.72 ± 0.53 |
| Treatment | Plant Fresh Weight (g) | Total Root Length (cm) | Stem Diameter (cm) | Plant Height (cm) | Root Surface Area (cm2) | Chlorophyll Content (SPAD) |
|---|---|---|---|---|---|---|
| CK | 5.12 ± 0.26 c | 375.82 ± 9.27 c | 0.43 ± 0.14 c | 14.00 ± 0.50 c | 39.56 ± 0.31 c | 37.20 ± 0.49 d |
| 106 | 9.31 ± 1.03 a | 1106.62 ± 14.61 a | 0.55 ± 0.23 a | 17.67 ± 0.58 a | 99.95 ± 1.66 a | 51.90 ± 1.41 a |
| 107 | 6.70 ± 0.67 b | 780.09 ± 79.63 b | 0.51 ± 0.36 ab | 16.00 ± 0.50 b | 83.92 ± 6.85 b | 41.17 ± 2.24 c |
| 108 | 7.77 ± 0.09 b | 1100.93 ± 36.67 a | 0.49 ± 0.09 b | 16.00 ± 1.00 b | 100.17 ± 8.04 a | 46.33 ± 2.06 b |
| Treatment | Percent Disease Index (PDI) (%) | Relative Control Rate (%) | Chlorophyll Content (SPAD) |
|---|---|---|---|
| AS | 100.00 ± 0 | - | 28.65 ± 0.85 d |
| AS + 106 | 0 ± 0 | 100.00 ± 0 | 45.20 ± 0.87 a |
| AS + 107 | 16.35 ± 0.35 | 83.15 ± 0.15 | 39.35 ± 0.9 c |
| AS + 108 | 28.60 ± 0.6 | 69.90 ± 0.9 | 41.43 ± 0.93 b |
| Gene Name | Length (bp) | Swiss-Prot Description | Organisms Comprising Orthologues Genes |
|---|---|---|---|
| Putative IAA production-related genes in B. velezensis YXDHD1-7 | |||
| trpA | 798 | Tryptophan synthase alpha chain | B. velezensis (strain DSM 23117/BGSC 10A6/LMG 26770/FZB42) |
| trpB | 1203 | Tryptophan synthase beta chain | B. velezensis (strain DSM 23,117/BGSC 10A6/LMG 26770/FZB42) |
| trpC | 753 | Indole-3-glycerol phosphate synthase | B. velezensis (strain DSM 23117/BGSC 10A6/LMG 26770/FZB42) |
| trpD | 1017 | Anthranilate phosphoribosyltransferase | B. velezensis (strain DSM 23117/BGSC 10A6/LMG 26770/FZB42) |
| trpE | 1548 | Anthranilate synthase component 1 | OS = B. subtilis (strain 168) |
| trpF | 654 | N-(5’-phosphoribosyl) anthranilate isomerase | B. velezensis (strain DSM 23117/BGSC 10A6/LMG 26770/FZB42) |
| Putative spermidine and polyamine production-related genes in B. velezensis YXDHD1-7 | |||
| msmX1 | 1107 | Uncharacterized ABC transporter ATP-binding protein YurJ | B. subtilis (strain 168) |
| msmX2 | 1101 | Oligosaccharides import ATP-binding protein MsmX | B. subtilis (strain 168) |
| pksS | 1212 | Polyketide biosynthesis cytochrome P450 PksS | B. subtilis (strain 168) |
| speE | 831 | Polyamine aminopropyltransferase | B. subtilis (strain 168) |
| speG | 459 | Spermine/spermidine N (1)-acetyltransferase | B. subtilis (strain 168) |
| Putative volatile compound production-related genes in B. velezensis YXDHD1-7 | |||
| alsD | 768 | Alpha-acetolactate decarboxylase | B. subtilis (strain 168) |
| ilvB | 1716 | Acetolactate synthase | B. subtilis (strain 168) |
| bdhA | 807 | Uncharacterized oxidoreductase YxjF | B. subtilis (strain 168) |
| bdhA | 786 | Uncharacterized oxidoreductase YxjF | B. subtilis (strain 168) |
| ilvB | 1725 | Acetolactate synthase large subunit | B. subtilis (strain 168) |
| acuC | 1167 | Acetoin utilization protein AcuC | B. subtilis (strain 168) |
| gapA | 1008 | Glyceraldehyde-3-phosphate dehydrogenase 1 | Bacillus subtilis (strain 168) |
| gapA | 1023 | Glyceraldehyde-3-phosphate dehydrogenase 2 | Bacillus subtilis (strain 168) |
| Putative biofilm formation, development, and regulation-related genes in B. velezensis YXDHD1-7 | |||
| iolU | 987 | Scyllo-inositol 2-dehydrogenase (NADP(+)) IolU | B. subtilis (strain 168) |
| rpoN | 1311 | RNA polymerase sigma-54 factor | B. subtilis (strain 168) |
| slrR | 456 | HTH-type transcriptional regulator SlrR | B. subtilis (strain 168) |
| csrA | 225 | Translational regulator CsrA | B. velezensis (strain DSM 23117/BGSC 10A6/LMG 26770/FZB42) |
| flgM | 267 | Negative regulator of flagellin synthesis | B. subtilis (strain 168) |
| wecB | 1140 | UDP-N-acetylglucosamine 2-epimerase | B. subtilis (strain 168) |
| tagA | 771 | N-acetylglucosaminyldiphosphoundecaprenol N-acetyl-beta-D-mannosaminyltransferase | B. subtilis (strain 168) |
| cysE | 654 | Serine acetyltransferase | B. subtilis (strain 168) |
| fliA | 765 | RNA polymerase sigma-D factor | B. subtilis (strain 168) |
| hfq | 222 | RNA-binding protein Hfq | B. velezensis (strain DSM 23117/BGSC 10A6/LMG 26770/FZB42) |
| sinR | 342 | HTH-type transcriptional regulator SinR | B. subtilis (strain 168) |
| luxS | 474 | S-ribosylhomocysteine lyase | B. velezensis (strain DSM 23117/BGSC 10A6/LMG 26770/FZB42) |
| crr | 507 | Putative phosphotransferase enzyme IIA component YpqE | B. subtilis (strain 168) |
| trpE | 1548 | Anthranilate synthase component 1 | B. subtilis (strain 168) |
| Cluster ID | Type | Similar Cluster | Similarity (%) | MIBiG Accession |
|---|---|---|---|---|
| 1 | Bacteriocin | Amylocyclicin | 100 | BGC0000616 |
| 2 | Other | Bacilysin | 100 | BGC0001184 |
| 3 | Lanthipeptide | Mersacidin | 100 | BGC0000527 |
| 4 | PKS-like | Butirosin A/butirosin B | 7 | BGC0000693 |
| 5 | terpene | - | - | - |
| 6 | TransAT-PKS | Macrolactin H | 100 | BGC0000181 |
| 7 | TransAT-PKS | Bacillaene | 100 | BGC0001089 |
| 8 | NRPS | Fengycin | 86 | BGC0001095 |
| 9 | TransAT-PKS | Difficidin | 46 | BGC0000176 |
| 10 | NRPS | Plipastatin | 53 | BGC0000407 |
| 11 | Terpene | - | - | - |
| 12 | T3PKS | - | - | - |
| 13 | TransAT-PKS-like | Difficidin | 53 | BGC0000176 |
| 14 | NRPS | Surfactin | 39 | BGC0000433 |
| 15 | NRPS | Surfactin | 47 | BGC0000433 |
| 16 | T1PKS | Macrobrevin | 26 | BGC0001470 |
| 17 | T3PKS | Myxovirescin A1 | 17 | BGC0001025 |
| 18 | TransAT-PKS-like | Difficidin | 26 | BGC0000176 |
| 19 | NRPS | - | - | - |
| 20 | NRPS | Fengycin | 13 | BGC0001095 |
| 21 | TransAT-PKS-like | Bryostatin | 80 | BGC0000174 |
| 22 | TransAT-PKS-like | - | - | - |
Disclaimer/Publisher’s Note: The statements, opinions and data contained in all publications are solely those of the individual author(s) and contributor(s) and not of MDPI and/or the editor(s). MDPI and/or the editor(s) disclaim responsibility for any injury to people or property resulting from any ideas, methods, instructions or products referred to in the content. |
© 2024 by the authors. Licensee MDPI, Basel, Switzerland. This article is an open access article distributed under the terms and conditions of the Creative Commons Attribution (CC BY) license (https://creativecommons.org/licenses/by/4.0/).
Share and Cite
Li, W.; Sun, L.; Wu, H.; Gu, W.; Lu, Y.; Liu, C.; Zhang, J.; Li, W.; Zhou, C.; Geng, H.; et al. Bacillus velezensis YXDHD1-7 Prevents Early Blight Disease by Promoting Growth and Enhancing Defense Enzyme Activities in Tomato Plants. Microorganisms 2024, 12, 921. https://doi.org/10.3390/microorganisms12050921
Li W, Sun L, Wu H, Gu W, Lu Y, Liu C, Zhang J, Li W, Zhou C, Geng H, et al. Bacillus velezensis YXDHD1-7 Prevents Early Blight Disease by Promoting Growth and Enhancing Defense Enzyme Activities in Tomato Plants. Microorganisms. 2024; 12(5):921. https://doi.org/10.3390/microorganisms12050921
Chicago/Turabian StyleLi, Wangxi, Lili Sun, Hangtao Wu, Wenjie Gu, Yusheng Lu, Chong Liu, Jiexin Zhang, Wanling Li, Changmin Zhou, Haoyang Geng, and et al. 2024. "Bacillus velezensis YXDHD1-7 Prevents Early Blight Disease by Promoting Growth and Enhancing Defense Enzyme Activities in Tomato Plants" Microorganisms 12, no. 5: 921. https://doi.org/10.3390/microorganisms12050921
APA StyleLi, W., Sun, L., Wu, H., Gu, W., Lu, Y., Liu, C., Zhang, J., Li, W., Zhou, C., Geng, H., Li, Y., Peng, H., Shi, C., Wang, D., & Peng, G. (2024). Bacillus velezensis YXDHD1-7 Prevents Early Blight Disease by Promoting Growth and Enhancing Defense Enzyme Activities in Tomato Plants. Microorganisms, 12(5), 921. https://doi.org/10.3390/microorganisms12050921

